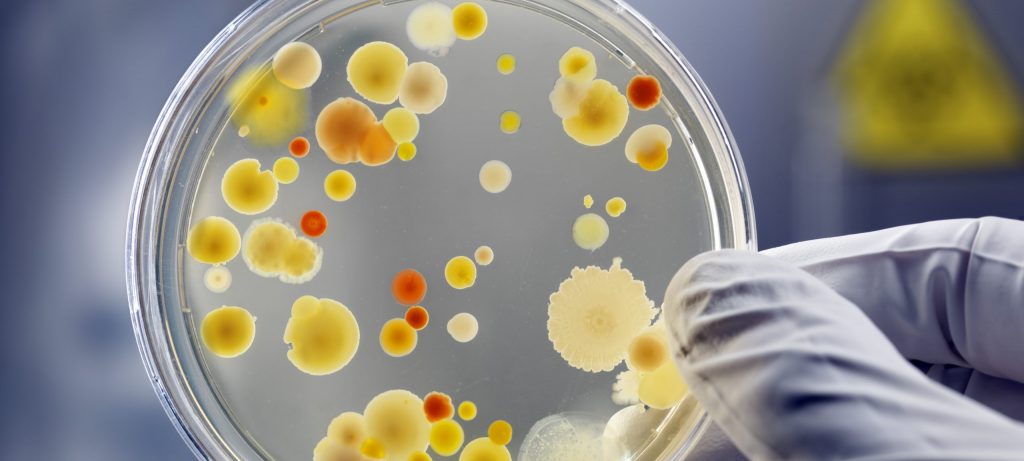

- <
- 2026
- 2025
- 2024
- 2023
- 2022
- 2021
- 2020
- >

Adam’s Journal I read an article about anti-aging drugs for dogs. Last I checked, we hadn’t even developed such a thing for people. Is this for real? And what might it mean – or not – for we two-legged creatures? Dr. Criley Prescribes It is, indeed, for real. Right now, there are two major trials […]
June 9, 2026

Adam’s Journal In my (deep sigh) seemingly never-ending odyssey to heal my torn hamstring, I recently visited a physician who suggested that I try peptides. I’ve heard a lot about them lately, but I confess I don’t really know what they are. Are peptides a safe and effective option for injuries like mine? Dr. Scofield […]
June 2, 2026

Adam’s Journal This week, we have a question from Carli Hartley, our co-worker at the Oklahoma Medical Research Foundation: Polycystic ovarian syndrome was recently renamed polyendocrine metabolic ovarian syndrome in hopes that it would help improve care for this disorder that impacts 1 in 8 women. As someone with the condition, I’m curious how this […]
May 26, 2026

Adam’s Journal By now, we’ve seen the headlines about the outbreak of hantavirus aboard a cruise ship earlier this month. Is this something we need to worry about? Dr. Scofield Prescribes The hantavirus is what’s known as a zoonotic virus, meaning it originates in animals and can be spread to humans. For most hantavirus strains, […]
May 19, 2026

I read that Indiana Pacers’ star — and 2025 Thunder championship nemesis — Tyrese Haliburton has been struggling for several months with a case of the shingles on his face. He’s only 26.
I thought shingles was more of a concern for older people, especially because vaccination recommendations start at age 50. Can and should you be vaccinated for shingles if you are younger than 50?
May 12, 2026

So, I’m going to pose a question that an audience member asked when you traveled around the state as part of the Oklahoma Medical Research Foundation’s “Spotlight Conversations” series:
Should we all be taking creatine?
May 5, 2026

I’ve seen low-cost heart scans advertised at local hospitals. I’ve never had one, but should I? Should we all? How useful are they?
April 29, 2026

The other night, despite a strong start, Texas Rangers pitcher Nathan Eovaldi seemed off his game. When the camera cut to him in the dugout, he was taking a big whiff of smelling salts.
What are smelling salts anyway? And do they really improve athletes’ performance? (I should note that Eovaldi pitched seven scoreless innings that night.)
April 21, 2026

With my basketball-watching now reaching its annual fever pitch – go Thunder! – I’m increasingly noticing players bearing the telltale signs of “cupping”: round, reddish bruises on their upper backs and shoulders.
Why do athletes have cupping treatments? And do they actually do anything?
April 14, 2026

My cat and I were hanging out and being lazy the other day. At some point, February got up from the sofa and let out a big yawn.
Febs snaps her teeth together at the end of her yawns, which I find adorable. But before I could say, “Awww,” I found myself yawning, too.
How did I catch yawning from my cat?
April 7, 2026

Here’s a question from an Oklahoma Medical Research Foundation coworker:
I heard someone say the other day that drinking room-temperature water was better for digestion than ice-cold. Is this true?
March 31, 2026

Here’s a question from a reader:
My mother-in-law has Parkinson’s disease. Is my wife at greater risk because her mother has it? Over the last couple of years, I’ve noticed my wife, who is 55, has a tremor in her hands that’s more pronounced when she’s holding her phone.
March 24, 2026

Before digging out all of our red, white and blue clothing to celebrate America’s 250th birthday this summer, my wife and I watched Ken Burns’ (excellent) documentary, “The American Revolution.” In the series, I was surprised to find that Burns highlighted smallpox. What role did it play in the colonies’ fight for independence?
March 17, 2026

On the heels of my last bout of Covid, things that used to taste good tasted bad or, sometimes, like not much at all. I know that loss of taste is a side effect of Covid, but should I worry? Could this signal other health issues?
March 10, 2026

Here’s a question from an Oklahoma Medical Research Foundation colleague:
Osteoporosis runs in my family, and I’ve heard that walking with a lot of force can help prevent it. Is stomping around a real treatment?
March 3, 2026

The daughter of one of my wife’s friends was recently diagnosed with something called stiff person syndrome. What is this condition? And what does the treatment landscape for it look like?
February 24, 2026

A friend’s toddler recently had some long-lasting gastrointestinal trouble. His pediatrician ordered a stool sample to rule out foodborne illness.
Although he didn’t have a bacterial infection, the results showed that some of the beneficial bacteria in his gut were either missing or significantly reduced. How does this happen? And how do you fix it?
February 17, 2026

When I watch the winter — or any — Olympics, I can’t help but wonder how many of the athletes I’m seeing are using performance-enhancing drugs. But maybe I’m being too cynical. Are there genetic mutations that fuel performances that might otherwise seem superhuman?
February 10, 2026

Not long ago, I was feeling rundown and had post-nasal drip, a sore throat and a headache. I feared it might be the flu, so I thought I’d better get a home test to check. I had just recently had Covid, so I was surprised to be positive again. But did the faintness of the line mean my case wasn’t serious?
February 3, 2026

As I approach my 58th birthday, I’m beginning to see the writing on the wall for running and me. Although the sport has served me well for four decades-plus, the injuries are piling up at a rate that’s becoming unsustainable.
If I want to stay active – and I do! – as I age, what other sports would you recommend?
January 27, 2026

My most memorable Christmas gift this past year was Covid, whose symptoms set in just in time to ruin the holiday. Even weeks after I’ve recovered, I continue to notice that my heart rate during exercise is a bit higher (10 beats per minute or so) than it typically would be during similar workouts. Should I be worried?
January 20, 2026

A young and generally healthy man was feeling run down, so he went to a wellness spa to receive an IV vitamin infusion. Shortly after the IV was hooked to his arm and the infusion began, he felt like he was blacking out.
He received an injection with an EpiPen, and this seemed to help for a bit. He apparently recovered quickly and is fine now. What do you think happened?
January 14, 2026

Flu seems to be everywhere these days, and this year’s flu season seems like it’s going to be worse than usual. Why is that?
January 6, 2026

Earlier this month, an advisory panel to the Centers for Disease Control voted to stop recommending hepatitis B shots at birth for most newborns. My understanding is that hepatitis B is usually transmitted sexually or through intravenous drug use. So, why would babies need to be vaccinated against this virus?
December 30, 2025

I've been told my knee needs a meniscus repair. My pain level is mostly moderate, and I don't take any pain relievers.
I've read this surgery isn't always successful, with a full knee replacement possible in the future. I've also heard about other treatments like platelet-rich plasma (PRP).
At 79, I'm not sure that I want to do this surgery. What pros and cons should I consider?
December 23, 2025

Our cat, February, consistently greets me with loud and persistent meows when I arrive home. This meowing seems to be louder and more persistent than when she greets my wife in similar circumstances. Any idea why this is?
December 16, 2025

I got a half-price holiday special offer for complete genome sequencing. It said the test would identify up to 15,000 early warning signs and potential health risks for $280. Do these kinds of tests provide useful information?
December 9, 2025

I’ve seen several recent news reports linking melatonin to heart failure. That sounds alarming. Do people using this sleep aid need to reconsider?
December 2, 2025

I read that on Thanksgiving, the average American will consume 4,500 calories.
This is one of those times when I’d actually like to be an underperformer. If I’m looking to curb the total amount of food I consume on Thursday, should I skip breakfast? Or am I better off eating early so that I don’t show up ravenous for the big Thanksgiving meal?
November 25, 2025

I saw that the Food and Drug Administration is removing safety warnings for hormone replacement therapy creams, pills and patches. Why the about-face? And what does this mean for menopausal and perimenopausal women?
November 18, 2025

Once someone with a latent TB infection is treated, will they continue to test positive? For how long? AND People my age (nearing 80) were immunized against TB as children. Does that mean we are latent, home free, or something else?
November 11, 2025

I recently had my gallbladder removed, and pretty much every nurse I talked to at the hospital said they had, too. If this is part of a larger trend, why is this happening? And how can we function without this organ if it's doing something important?
November 4, 2025

My wife signed up to volunteer at a hospital, and as part of that process, she received a blood test for tuberculosis. It came back positive.
She’s undergone a chest x-ray, which came back negative. And she has no symptoms. So, what does this all mean?
October 28, 2025

GLP-1 drugs like Ozempic, Wegovy and Mounjaro have transformed the field of weight loss. Now I’ve started hearing and reading stories of how the drugs can also curb addiction to alcohol and drugs. Are these just anecdotes, or is there more to it?
October 21, 2025

I’ve read a lot of recommendations about protein intake in the diet. In particular, I’ve seen many suggestions that adults, especially older ones, increase the amount of protein they consume on a daily basis.
October 14, 2025

Last month, the Food and Drug Administration urged physicians to exercise caution in recommending or prescribing acetaminophen during pregnancy, linking its use to autism and ADHD. This followed statements from the president and other high-level federal officials fingering the pain reliever as a cause of autism. What does the scientific evidence say?
October 7, 2025

Covid vaccinations always seem to be controversial. Have any studies been conducted regarding the effectiveness of these shots?
September 30, 2025

We have medical marijuana in Oklahoma, and we may be soon voting – again – on recreational marijuana. As an employer, I am concerned about the health of my employees who use marijuana. What do we know about the short- and long-term effects of marijuana use?
September 23, 2025

My wife and I have recently begun tracking our sleep; I use an Oura Ring and she uses a Garmin watch. The devices not only tell us how long we’ve slept but they also rate the quality of our sleep, tracking how much time we’ve spent in different types of sleep.
What are the different types of sleep, and why are they important?
September 16, 2025

I read about a new case of malaria in New Jersey. Huh? I thought malaria had been eradicated in this country.
September 9, 2025

One of my friends recently told me they had been fasting for four days, water only, and had read about the many health benefits of long-term fasting for resetting your body. Are there health benefits for this kind of fast? And if there are benefits, do they outweigh the risks?
September 2, 2025

A colonoscopy recently revealed colon polyps – and a recommendation for another colonoscopy in three years. My younger sister’s colonoscopy yielded similar results.
Neither of us seems to have many, if any, of the typical lifestyle risk factors for polyps. How big a role does genetics play?
August 26, 2025

I read that a company recently succeeded in bringing back the dire wolf, a species that went extinct more than 10,000 years ago. How’d they do it? And what does this mean for other long-gone species like the dodo and woolly mammoth?
August 19, 2025

My friend says that after he eats asparagus, his pee immediately has a distinctive odor. I, on the other hand, have never noticed any difference in the smell of my urine when I’ve consumed asparagus. Who’s the weird one here?
August 12, 2025

Last week, I saw a news report about new findings on preventing dementia. The story said a large study had found that behavioral changes in older people could help reduce the chances of cognitive decline. Please tell me more!
August 5, 2025

I was diagnosed with Crohn’s disease in my early 30s, and there have been a lot of ups and downs in the years that have followed. After my most recent colonoscopy, my doctor said I am in “endoscopic and pathologic” remission.
What does the term remission mean? Does it mean different things for different patients and diseases?
July 29, 2025

By Adam Cohen I’m not quite sure when my father first said he wanted us to spread his ashes from the summit of Capitol Peak. But it probably happened soon after my mother survived breast cancer – and promptly left him. This might sound cruel, but from my vantage point, my parents’ marriage had never […]
July 22, 2025

With schools out and temperatures surging, we’re in the heart of pool season. From a safety perspective, when is a good time to start teaching children to swim?
July 15, 2025

In case you haven’t noticed, it’s gotten kind of soupy out there. Not surprisingly, the summer’s heat and humidity have been most evident during my morning runs. I feel like I should be apologizing to my wife for the sweat-saturated clothes that decorate our bathroom for the remainder of the day.
How much water do I need to be drinking to replace all that lost fluid? Is the usual recommendation of eight glasses a day sufficient?
July 8, 2025

As pretty much every Oklahoma City Thunder fan knows, Indiana Pacers’ star Tyrese Haliburton entered game 7 of the NBA Finals with a calf strain. He made the decision to play, and within minutes he ruptured his Achilles tendon.
What’s the likelihood these two injuries were related?
July 1, 2025

I’ve been reading about taking anti-inflammatory medications as an arthritis preventative lately, and I wondered how effective they are. Chondroitin sulfate seems to be the most popular. Even my dog is now on it.
Please weigh in here. Is it actually helpful? My dog and I want to know.
June 24, 2025

Two friends were recently diagnosed as prediabetic. Like me, they’re both in their later 50s, and they’re both active and not overweight. I was surprised by their diagnoses, as neither seems to have the hallmarks of Type 2 diabetes.
June 17, 2025

I just read about a new study that linked drinking coffee to aging healthily. Starbucks and Folgers must have pretty good PR people because I’ve lost count of how many times I’ve seen similar headlines over the years. Are the health benefits of coffee real, or is this marketing masquerading as science?
June 10, 2025

I should open by stating that I have no plans to climb Mount Everest, nor any similar peak. But I have always been intrigued by high-altitude mountaineering, and my interest was piqued when I read about a British expedition this year that summited the world’s tallest mountain not long after inhaling xenon gas.
Can breathing in a gas really make a person a better mountaineer? And is it dangerous?
June 3, 2025

Former President Biden has been diagnosed with a form of prostate cancer that has been described as “aggressive.” Obviously, that’s not good news for him and his family, but what does it mean in terms of prognosis and treatment options?
May 27, 2025

My wife recently picked up one of my all-time favorite brownies for me, but on the way home, she dropped it on the sidewalk. She couldn’t bear to throw it out, so she scooped it up and left the eat-or-toss decision to me.
May 20, 2025

I’ve seen articles claiming semaglutides like Ozempic and Wegovy can reduce the risk for a rash of conditions, including dementia and alcohol use disorder. Is it the medicine having this impact, or is it the resulting weight loss?
May 13, 2025

There are certain smells that conjure a specific time or place for me. That scent that comes with an electrical storm takes me to the New Hampshire lake where I used to spend summers as a child. The aroma of maple-scented coffee brings me a picture of my wife as she makes her way back to bed each morning to do a crossword puzzle before confronting the day.
Is it just me, or is there a special link between our noses and our memories?
May 6, 2025

It seems that pretty much every time I go to the doctor’s, someone – or some form – asks me if I’m allergic to latex. Happily, I’m not. But it always strikes me as sort of strange that some people would have an allergy to rubber. Is this common?
April 29, 2025

I got the shingles vaccine a few years ago to – you guessed it – protect me from shingles. Now I hear it might also have beneficial effects when it comes to preventing Alzheimer’s. I am, of course, quite happy about this news, but it seems weird.
April 22, 2025

Please set me straight once and for all: Do I need to take 10,000 steps a day if I want to be my best self?
April 15, 2025

From the too-good-to-be-true category comes the following headline I recently saw: The People Who Never Get Hangovers. Do such people really exist? If so, how do I join this group?
April 8, 2025

I keep seeing headlines about cats contracting bird flu. Should my wife and I be exercising any sort of precautions when it comes to our cat , February, or being around her? Unfortunately, I think getting Febs to wear a mask is not a realistic option.
April 1, 2025

My wife and I visited New York earlier this month, and Mary was – no kidding – disappointed that she didn’t spy a single rat. I, however, did, witnessing one scurry across a subway platform as I awaited an early-morning train. Happily, it had no interest in me, and it quickly vanished into an opening in some sort of utility box.
March 25, 2025

I’m not much of a conspiracy theorist. But others have shared with me a belief that a cure for cancer actually exists; it is just being kept from us by big pharma so that they can make money on cancer treatments. What do you think?
March 18, 2025

I saw a headline claiming that cursing can help with pain management. C’mon. That can’t be real, can it?
March 11, 2025

I’m in my 60s, and the new measles outbreak in West Texas has me wondering: Does my childhood vaccine provide lifetime protection from the measles, or do I need a booster shot?
March 4, 2025

We just survived what I hope will be the last arctic blast of this winter. And, wow, was it freezing out there. Is there any way we can prepare our bodies to better weather (sorry – Dad joke) the cold?
February 25, 2025

Last month, the Food and Drug Administration approved Journavx, a new drug to treat pain. I read that it is the first new prescription pain medication in more than 25 years. That sounds like a big deal. Is it?
February 18, 2025

My wife recently read a book recommending that everyone wear a continuous glucose monitor to track their blood sugar levels. What do you think?
February 11, 2025

I read an article saying that when it comes to how long we live, only about 25% is determined by our genes, with the remaining 75% due to our lifestyle. Is this true?
February 4, 2025

It seems like I’ve recently started seeing lots of ads recommending the pneumococcal pneumonia vaccine for those who, like me, are over 50. I thought I was up to date on my shots, but I’m pretty sure I’ve never had this one. Did something change?
January 28, 2025

Throughout the NFL season and now the playoffs, I’ve noticed an occasional player wearing what appears to be an oversized helmet. When I did a quick internet search, I found that these were “Guardian Caps,” padded helmet covers that football players can use to protect themselves from brain injuries. Do they work?
January 22, 2025

My husband recently had a fairly minor carpal tunnel surgery, and his doctor prescribed oxycodone for him. We’ve seen so many bad things about it that he was nervous to take it. However, when we asked, the doctor said that’s all she would prescribe (other than a similar narcotic) but that if he preferred, he could instead take over-the-counter medications like Tylenol or ibuprofen. Is it ever safe to take an opioid like oxycodone, or is it better to just stay away if possible?
January 14, 2025

It seems that quite a few friends and coworkers have come down with stomach bugs in the past month or so. Is it just a coincidence, or is there a larger trend at work here?
January 7, 2025

Sandwiched among the family, the friends, the events, the gifts, and the meals (oh, so many meals!), I like to find a moment or two for reflection at this time of year. To frame things, I dug up my very first health and fitness column for The Oklahoman, which appeared in early 2007. My column […]
December 31, 2024

Adam’s Journal ‘Tis the season – for another question from an Oklahoma Medical Research Foundation coworker: The blood work following my recent annual exam showed low iron levels. My primary-care physician says he wants to see me again to rule out anemia. I’d rather avoid taking time out from work for another trip to the […]
December 24, 2024

Adam’s Journal Here’s a question from a fellow Oklahoma Medical Research Foundation employee: Why does dry skin get worse in the winter? And what can I do about it? Dr. James Prescribes The skin serves like the walls of a building, protecting it from outside forces while also keeping everything that belongs on the inside […]
December 17, 2024

Adam’s Journal Over Thanksgiving, my son mentioned to me that he’d been having some issues with lactose intolerance. However, he said he’d overcome them through something I will call a dairy boot camp, where he consumed a lot of milk products to train his gut to tolerate them. This was the first I’d heard that […]
December 10, 2024

Adam’s Journal In addition to your day job as a physician-researcher at the Oklahoma Medical Research Foundation, I know you spend a good deal of time and energy as a referee for youth soccer. With the fall season recently having come to an end, I wondered whether there were any issues that stood out to […]
December 3, 2024

Adam’s Journal This week, I had a question about an important member of the Cohen household for Dr. Jennie Criley, the attending veterinarian at the Oklahoma Medical Research Foundation: We moved to a new home this fall, and since that time, our cat, February, has been meowing a lot. And loudly. She’s 15 years old. […]
November 26, 2024

Adam’s Journal Here’s a timely question from a longtime reader – and Oklahoma City Thunder fan: I read about a few recent National Basketball Association player injuries and wondered: Are extra-tall people just prone to more injuries and broken bones? Can you grow so tall that you outgrow the density of your bones? Specifically, this […]
November 19, 2024

Adam’s Journal I ran the New York City Marathon earlier this month. After I crossed the finish line, exhausted, I looked at my watch. Like many smart devices, it makes recommendations about the amount of recovery time I need following a workout. On the heels of this 26.2-mile effort, it said 72 hours. Huh? Seriously? […]
November 12, 2024

Adam’s Journal For years, I’ve read that people in “blue zones” live longer because of their diets and lifestyles. But I just heard about a study that’s called this into question. What’s the story? Are blue zones for real – or just more wellness hype? Dr. Scofield Prescribes The term “blue zone” first appeared in […]
November 5, 2024

Adam’s Journal An Oklahoma Medical Research Foundation coworker would like your opinion on the use of magnets to treat pain. In particular, she says her mother has gotten relief by using a magnet – I believe it’s enclosed in a wrap – to treat shoulder pain. Dr. Scofield Prescribes The idea of using magnets as […]
October 29, 2024

Adam’s Journal Here’s a question from a reader: Does Prevagen truly help memory retention, or is this just hype? Sue Bozeman Oklahoma City Dr. Scofield Prescribes I’m probably the perfect demographic, but it seems like Prevagen ads come on every time I turn on the TV. Maybe you’ve seen the commercials, too: “After taking Prevagen, […]
October 22, 2024

Adam’s Journal I had the best of intentions. Really, I did. I thought this was the year I was going to make good on a Sober October. But I only made it six days before I broke my pledge by having a cocktail. (I swear it was a small one!) Then, four days later, I […]
October 15, 2024

Adam’s Journal Not long ago, I read an article suggesting that physicians were moving away from the body mass index as a medical screening tool. But when I went for a physical last month, my BMI was printed right at the top of the summary I received at the end of my visit. Is my […]
October 8, 2024

Adam’s Journal Almost six months ago, I suffered a hamstring injury while running. It is no exaggeration to say that (caution, Dad joke ahead) it’s been hamstringing me ever since. I’ve tried rest, cross-training, stretching and rehab exercises, but nothing has seemed to work. A friend recently suggested a platelet-rich plasma injection. What do you […]
October 1, 2024

Adam’s Journal I saw a headline that the Food and Drug Administration has approved Apple AirPods as hearing aids. Seriously? Is this some sort of marketing ploy by Apple? Dr. Scofield Prescribes Your eyes did not deceive you. And while I understand your skepticism, this has the potential to be a major benefit for many […]
September 24, 2024

Adam’s Journal ‘Tis the season – for pharmacies to advertise flu shots. Pretty much every drugstore I pass seems to be encouraging folks to come in and get their annual flu shots. Is now the right time to get vaccinated? Dr. Scofield Prescribes In life, getting a jump start on things is often a good […]
September 17, 2024

Adam’s Journal During a hiking trip, a friend relayed a piece of advice she’d received: To prevent altitude sickness, take an antacid. Now, when she and her husband head to the mountains, they chew on Tums. Is there any merit to this approach? Dr. Scofield Prescribes Hmm. This was a new one for me. But […]
September 10, 2024

Adam’s Journal My son just had his tonsils out. In the days after his surgery, he’s been running a low-grade fever. His doctor told him not to be concerned, so long as his temperature stays around 100 degrees and doesn’t linger too long. Still, as a parent, I can’t help but worry. Couldn’t he have […]
September 3, 2024

Adam’s Journal Here’s a question from an Oklahoma Medical Research Foundation coworker: My wife and I are about to go on a long-anticipated trip to Europe. I got my last Covid booster almost a year ago, and I’m in my early 60s. Given the number of cases going around now, should I get another shot […]
August 27, 2024

Each week, OMRF Chief Medical Officer Dr. Judith James opens “Adam’s Journal” to answer a medical question from Adam Cohen, OMRF’s senior vice president & general counsel. Adam’s Journal My wife had what she describes as a “bad” reaction to a bee sting as a second grader. To her knowledge, Mary has never again been […]
August 20, 2024

Each week, OMRF Chief Medical Officer Dr. Judith James opens “Adam’s Journal” to answer a medical question from Adam Cohen, OMRF’s senior vice president & general counsel. Adam’s Journal I was extremely grateful to my physician when he gave me a prescription for Paxlovid to treat a recent case of Covid. But as soon as […]
August 16, 2024

Each week, OMRF Chief Medical Officer Dr. Judith James opens “Adam’s Journal” to answer a medical question from Adam Cohen, OMRF’s senior vice president & general counsel. Adam’s Journal One recent morning, my Apple Watch alerted me that it had detected a change in my resting heart rate. Specifically, my baseline pulse had increased over […]
August 6, 2024

Each week, OMRF Chief Medical Officer Dr. Judith James opens “Adam’s Journal” to answer a medical question from Adam Cohen, OMRF’s senior vice president & general counsel. Adam’s Journal I just returned from a delicious dinner where I ate a mouth-wateringly good plate of noodles seasoned at what was advertised as a “medium” spice level. […]
July 30, 2024

Each week, OMRF Chief Medical Officer Dr. Judith James opens “Adam’s Journal” to answer a medical question from Adam Cohen, OMRF’s senior vice president & general counsel. Adam’s Journal Here’s a question from one of our coworkers at the Oklahoma Medical Research Foundation: My doctor changed my medication to something he referred to as a […]
July 23, 2024

Outside of Aspen, Colorado, there’s a rock-climbing route that bears my father’s name. Like just about everything associated with Dad, the route’s name is clever. And, just as fitting, it’s tough. This ascent was perhaps Dad’s greatest challenge as an alpinist. So, when he conquered it, whoever bestows these monikers did themselves – and my […]
July 16, 2024

Each week, OMRF Chief Medical Officer Dr. Judith James opens “Adam’s Journal” to answer a medical question from Adam Cohen, OMRF’s senior vice president & general counsel. Adam’s Journal Here’s a question from a reader: What’s the difference between viruses and bacteria? Peggy Anderson Moore Dr. James Prescribes Bacteria and viruses are often lumped together […]
July 9, 2024

If you think of a spokesperson, it’s hard not to hear a voice. After all, it’s right there in the word itself: spoke, the past tense of “to speak.” But every once in a while, there’s someone who becomes a spokesperson without ever saying a word. That was Sam Weyrich. Sam was born with an […]
July 2, 2024

Each week, OMRF Chief Medical Officer Dr. Judith James opens “Adam’s Journal” to answer a medical question from Adam Cohen, OMRF’s senior vice president & general counsel. Adam’s Journal With the arrival of summer and its soaring temperatures, I’ve been searching for some silver linings. Although doing just about anything in the heat is less […]
June 25, 2024

Each week, OMRF Chief Medical Officer Dr. Judith James opens “Adam’s Journal” to answer a medical question from Adam Cohen, OMRF’s senior vice president & general counsel. Adam’s Journal I read recently that 4 in 10 people 65 and older suffer from some form of memory loss. And I assume that our brains, like so […]
June 18, 2024

Each week, OMRF Chief Medical Officer Dr. Judith James opens “Adam’s Journal” to answer a medical question from Adam Cohen, OMRF’s senior vice president & general counsel. Adam’s Journal I visited my mother this past week, and on the heels of her 88th birthday, she remains her usual joyful, sunny self. However, she’s showing some […]
June 11, 2024

OMRF attending veterinarian Dr. Jennie Criely opens “Adam’s Journal” to answer a medical question from Adam Cohen, OMRF’s senior vice president & general counsel. Adam’s Journal This week, Dr. Jennie Criley, the attending veterinarian at the Oklahoma Medical Research Foundation, graciously interrupted her vacation to answer my question: So, after almost a year of marriage […]
June 4, 2024

Each week, OMRF Chief Medical Officer Dr. Judith James opens “Adam’s Journal” to answer a medical question from Adam Cohen, OMRF’s senior vice president & general counsel. Adam’s Journal A bump recently appeared above my wife’s eye, near the edge of her eyebrow. It grew inflamed and painful, which led to a course of antibiotics. […]
May 28, 2024

Each week, OMRF Chief Medical Officer Dr. Judith James opens “Adam’s Journal” to answer a medical question from Adam Cohen, OMRF’s senior vice president & general counsel. Adam’s Journal Here’s a question from an Oklahoma Medical Research Foundation coworker: My grandma loves grapefruit, but she hasn’t had one in years because of possible interactions with […]
May 21, 2024

Each week, OMRF Chief Medical Officer Dr. Judith James opens “Adam’s Journal” to answer a medical question from Adam Cohen, OMRF’s senior vice president & general counsel. Adam’s Journal Like many employers, the Oklahoma Medical Research Foundation teams with a mobile mammography service to offer onsite breast cancer screening services to our employees. An employee […]
May 14, 2024

Each week, OMRF Chief Medical Officer Dr. Judith James opens “Adam’s Journal” to answer a medical question from Adam Cohen, OMRF’s senior vice president & general counsel. Adam’s Journal I recently heard reports that the bird flu virus has been detected in supplies of milk. Should we be worried about drinking milk? Is there a […]
May 7, 2024

Each week, OMRF Chief Medical Officer Dr. Judith James opens “Adam’s Journal” to answer a medical question from Adam Cohen, OMRF’s senior vice president & general counsel. Adam’s Journal My sister recently completed the Boston Marathon. (Please indulge a brief moment of brotherly bragging: My sister, Ali, is a phenomenal athlete!) She started out with […]
April 30, 2024

Each week, OMRF Chief Medical Officer Dr. Judith James opens “Adam’s Journal” to answer a medical question from Adam Cohen, OMRF’s senior vice president & general counsel. Adam’s Journal I’ve recently read and heard about testing for something called Apo B. In particular, I’ve been told that it can be a more accurate predictor for […]
April 23, 2024

Adam Cohen, OMRF’s senior vice president & general counsel answers a a medical question submitted by a reader. Adam’s Journal Dear Adam, My teenage son, a 7-day-a-week basketball player, occasionally gets blisters on the bottom of his feet. Because he is continually practicing for his school team and his AAU team, there’s no real downtime […]
April 16, 2024

OMRF attending veterinarian Dr. Jennie Criely opens “Adam’s Journal” to answer a medical question from Adam Cohen, OMRF’s senior vice president & general counsel. Adam’s Journal Our fabulous dogs are getting older, so we decided to get a new puppy. He’s making us crazy, and we’re wondering what we were thinking. It also led us to […]
April 9, 2024

OMRF physician-scientist Dr. Hal Scofield opens “Adam’s Journal” to answer a medical question from Adam Cohen, OMRF’s senior vice president & general counsel. Adam’s Journal Here’s a question from a reader: About 15 years ago at my yearly check-up, my physician asked if I drink alcohol. When I replied that I enjoyed a beer or […]
April 2, 2024

Each week, OMRF Chief Medical Officer Dr. Judith James opens “Adam’s Journal” to answer a medical question from Adam Cohen, OMRF’s senior vice president & general counsel. Adam’s Journal Here’s a question from a reader: I’m a 77-year-old male who’s very active. For years, I’ve gotten the annual flu vaccine in mid-October. This year, in […]
March 26, 2024

Each week, OMRF Chief Medical Officer Dr. Judith James opens “Adam’s Journal” to answer a medical question from Adam Cohen, OMRF’s senior vice president & general counsel. Adam’s Journal I just read of a case of a man who received 217 Covid booster shots. My first reaction when I saw that number was to check […]
March 19, 2024

Each week, OMRF Chief Medical Officer Dr. Judith James opens “Adam’s Journal” to answer a medical question from Adam Cohen, OMRF’s senior vice president & general counsel. Adam’s Journal Here’s a question from our Oklahoma Medical Research Foundation colleague – and Dr. James’ fellow OMRF scientist – Dr. Dean Dawson: The last couple of years […]
March 12, 2024

Each week, OMRF Chief Medical Officer Dr. Judith James opens “Adam’s Journal” to answer a medical question from Adam Cohen, OMRF’s senior vice president & general counsel. Adam’s Journal Here’s a question from my son: Recently, I’ve been eating a fair amount of eggs and salmon, both of which have a lot of dietary cholesterol, […]
March 5, 2024

Each week, OMRF Chief Medical Officer Dr. Judith James opens “Adam’s Journal” to answer a medical question from Adam Cohen, OMRF’s senior vice president & general counsel. Adam’s Journal A friend of mine is (surprise!) a runner, and as he’s aged, his knees have grown creakier and more painful. When I asked him if he […]
February 27, 2024

Each week, OMRF Chief Medical Officer Dr. Judith James opens “Adam’s Journal” to answer a medical question from Adam Cohen, OMRF’s senior vice president & general counsel. Adam’s Journal I’ve seen a lot of headlines recently about the new generation of weight-loss drugs. Now that their use is becoming more widespread, what are we learning […]
February 20, 2024

Each week, OMRF Chief Medical Officer Dr. Judith James opens “Adam’s Journal” to answer a medical question from Adam Cohen, OMRF’s senior vice president & general counsel. Adam’s Journal I read recently that many autoimmune illnesses, including Sjögren’s disease, are becoming more common. What is Sjögren’s, and why is it on the rise? Dr. James […]
February 13, 2024

Each week, OMRF Chief Medical Officer Dr. Judith James opens “Adam’s Journal” to answer a medical question from Adam Cohen, OMRF’s senior vice president & general counsel. Adam’s Journal Not long ago, a friend, who is otherwise healthy, recovered from Covid. However, after he was seemingly better, he’s had periodic episodes of his heart beating […]
February 6, 2024

Each week, OMRF Chief Medical Officer Dr. Judith James opens “Adam’s Journal” to answer a medical question from Adam Cohen, OMRF’s senior vice president & general counsel. Adam’s Journal At this time of year, many people suffer from sinus inflammation, congestion and various respiratory infections. Can rinsing your sinuses with saltwater using a neti pot […]
February 1, 2024

Each week, OMRF Chief Medical Officer Dr. Judith James opens “Adam’s Journal” to answer a medical question from Adam Cohen, OMRF’s senior vice president & general counsel. Adam’s Journal With the recent uptick in Covid-19 cases prompted by the JN.1 variant, I’ve wondered how effective Paxlovid is in treating these cases, especially in older people. […]
January 23, 2024

With the recent Arctic blast, exercising outdoors seems about as enticing as licking an icy flagpole. Still, if you opt to forgo the cozy confines of your home (or the gym) and brave the elements for a workout, be sure to make some adjustments to your routine. It may require some planning and preparation, but […]
January 16, 2024

Adam’s Journal Here’s a question from a reader: Dear Adam, Now in my 80s, I find myself paying more attention to aging and health issues, especially reducing dementia risks. I am aware that if nothing else gets me first, dementia is inevitable. I hope the Oklahoma Medical Research Foundation keeps dementia research on the forefront. Niles […]
January 9, 2024

Adam’s Journal Here’s a question from a reader: Dear Adam, I know you are a regular exerciser, and so am I. My stroke and spinal cord injuries have left me with few alternatives for exercise, but I use the ones that I can. At my local gym, I notice several people over the age of […]
January 5, 2024

Before we welcome 2024, let’s take a look back at what we learned about health in 2023.
December 26, 2023

In a spirit of holiday giving, Adam Cohen provides answers to some big holiday health questions.
December 19, 2023

I’ve heard reports about a surge in cases of respiratory illness in China. Do we need to worry about another novel virus like when Covid emerged?
December 12, 2023

Each week, OMRF Chief Medical Officer Dr. Judith James opens “Adam’s Journal” to answer a medical question from Adam Cohen, OMRF’s senior vice president & general counsel. Adam’s Journal I vaguely remember hearing about RSV in the past, but only as an illness that affects infants. Now, I commonly hear it discussed as a threat […]
December 5, 2023

When I was growing up, it seemed like every other kid I knew had their tonsils removed, but now it seems much rarer. When should a person have their tonsils removed?
November 28, 2023

A new weight-loss drug was recently approved. How is it different from the options on the market?
November 21, 2023

You’d think that after 3½ years of living with the virus, I would know Covid rules better...
November 14, 2023

I’ve noticed that my hands seem to feel colder than in the past when I spend time outside. Should I be worried?
November 7, 2023

Each week, OMRF Chief Medical Officer Dr. Judith James opens “Adam’s Journal” to answer a medical question from Adam Cohen, OMRF’s senior vice president & general counsel. Adam’s Journal As we often do when we get together, my sister and I recently found ourselves in a friendly competition. This one was to see if we […]
October 17, 2023

What is the best schedule for getting a booster vaccine, and how does Covid-19 infection affect that timeline?
October 3, 2023

Are the Covid-19 test kits we have been getting still valid for use with the newest strains of the virus?
September 26, 2023

Our daughter recently began her first semester at the University of Oklahoma. I’m wondering if we need to have her boosted again.
August 29, 2023

It seems autoimmune diseases like lupus and multiple sclerosis have been on the rise. Is my perception a product of my surroundings, or has there really been a surge?
August 22, 2023

I read recently that a fitness measurement called VO2 max is also a strong predictor of longevity. What is VO2 max, and can it really help tell how long we’ll live?
August 15, 2023

I know that our lifespans are determined by a combination of nature and nurture. But if you had to pick a number, just how much of a role do genes play in our longevity?
August 8, 2023

My father and one of my sons have a strange reaction when they look directly at the sun or a bright light: They sneeze.
August 1, 2023

I’ve heard that the World Health Organization declared aspartame a carcinogen. As regular Diet Coke and Coke Zero drinker, should I be worried?
July 18, 2023

Does working out in the heat – as opposed to a cooler, more comfortable environment – have any additional benefits?
July 11, 2023

Despite years of hearing otherwise, I recently read that even moderate alcohol consumption has no health benefits.
July 4, 2023

Pretty much everywhere I turn, I hear a new story about artificial intelligence. Has AI yet begun to impact the practice of medicine? And how might it affect how physicians and other providers care for patients in the future?
June 27, 2023

For as long as I can remember, I’ve heard that we should aim to take 10,000 steps a day. Where does this number come from, and does it really hold true as a universal standard for wellness and physical activity?
June 20, 2023

How would an insect bite cause a staph infection? Do bugs carry staph that can infect humans?
May 30, 2023

We had a blood drive recently at the Oklahoma Medical Research Foundation. When I complimented a coworker for participating, he mentioned it takes the body 56 days to “replenish” that pint of donated blood. Is that true?
May 23, 2023

We’ve all heard of strep throat. But now there's something called “invasive strep,” which I read is on the rise. What is it, and should we be worried?
May 16, 2023

A friend has a parent who lives with Alzheimer’s disease. Because of her family history, she has been offered a blood test to assess her own risk for Alzheimer’s. How accurate are these types of tests – and how useful are they?
May 9, 2023

My son was recently diagnosed with swimmer’s ear. But I don’t think he’s been in a pool in years. What gives?
May 2, 2023

Over the years, I’ve heard countless times that crosswording also helps ward off dementia. Is this true?
April 25, 2023

A friend told me her preschool-age daughter likely has fifth disease. I’ve never heard of it, but it sounds scary. Is it?
April 18, 2023

I’ve heard a lot about a new generation of weight-loss drugs that have become quite popular. What are they, and how effective are they?
April 11, 2023

A friend who recently turned 50 is beginning to experience some symptoms of menopause, so her physician brought up the possibility of hormone replacement therapy.
April 4, 2023

I’ve heard that the mere sight of a physician’s white coat can drive up a person’s blood pressure. Is this a real thing?
March 21, 2023

A friend sent me an article suggesting that gravity might be a factor in causing irritable bowel syndrome. Could this really be true? And if so, what does it mean for people affected by this condition?
March 14, 2023

Each week, OMRF Vice President of Research Dr. Rod McEver opens “Adam’s Journal” to answer a medical question from Adam Cohen, OMRF’s senior vice president & general counsel. Adam’s Journal Here’s a question from a reader: Dear Dr. McEver, I got my fourth Covid vaccination in September. I am at high risk because of my […]
March 7, 2023

I’ve heard products advertising their benefits for “gut health.” What exactly is that, and how would I even know if my gut is healthy – or not?
February 28, 2023

I recently read an article claiming that there's never been a better time to be short.
February 26, 2023

As someone who’s (relatively) newly engaged, I know the happiness that love brings. Surely, that happiness must also mean good things for a person’s health? Inquiring Valentine’s Day minds want to know!
February 12, 2023

My sister is a 48-year-old vegetarian and a marathoner. Recently, she was feeling fatigued, and a friend suggested she have her iron levels tested. The results showed that her ferritin levels were low. What does this mean? Should she worry?
February 7, 2023
While watching the NFL playoffs, I’ve noticed a number of players wearing what looks like a collar around their necks. It’s not attached to anything, and it’s not bulky like a typical pad. Any idea what this is and why players are wearing it?
January 31, 2023

My friend's chemo treatment caused him to lose his hair temporarily. His formerly straight hair is now curly. Is this normal?
January 24, 2023

Last week, we talked about nutrition when you have a cold or other respiratory virus. But what about treatments? How well do over-the-counter medicines work, especially when it comes to relieving stuffiness and congestion?
January 17, 2023

With the many respiratory viruses going around, I’m reminded of an old adage: Feed a cold and starve a fever. Does this time-worn advice hold true?
January 10, 2023

Every new year, one of my fiancée’s resolutions is to eat more broccoli. If I were to make some dietary resolutions for 2023, what would you recommend?
January 3, 2023

For the long-term strength of my vision, is it better to switch to a higher magnification now or hang on with current level as long as I can?
December 20, 2022

I read about a clinical trial using gene therapy in a group of Alzheimer’s patients. I’ve heard the term a lot, but what, exactly, is gene therapy?
December 13, 2022

I recently returned from Minnesota, where the mercury dipped into the single digits, and winds made it feel even chillier. Can it be too frigid to exercise, or did I just find a convenient excuse?
December 6, 2022

‘Tis the season – for my fiancée’s cat, February, to eat the “pine needles” off of her artificial Christmas tree.
November 29, 2022

I read recently that something like 90% of American children are now vaccinated for chickenpox. What does that mean for their risk for shingles?
November 22, 2022

Daylight saving time recently ended. When it did, I saw some headlines saying that it’s bad for our health. Seriously?
November 15, 2022

It seems like there are more births by cesarean section these days than, say, 20 years ago when my kids were born (both by C-section). Is this my imagination?
November 8, 2022

What, if anything, do researchers know about the long-term impact of Covid-19 on people’s fitness levels?
October 25, 2022

Can exercise — and especially long and intense sessions — compromise our immune systems?
October 20, 2022

How long does immunity from a flu shot last? Would a booster after the first shot help?
October 11, 2022

I read there may be a 'right' way to swallow a pill, or at least a more efficient method. Is that true?
October 4, 2022

I read that anxiety screening is now recommended for all adult patients under age 65. What’s involved in a screening, and why the upper age limit?
September 27, 2022

I’ve heard that females are much more likely to suffer ACL injuries in their knees than males. Is this true?
September 20, 2022

Before my kids were born, we had to decide whether to pay for umbilical cord blood banking. We chose not to, but in the ensuing 20-plus years, I’ve continued to see ads targeted at new parents for this service. Is it worthwhile?
September 13, 2022

My preschooler and I recently had hand, foot and mouth disease. I’ve read that some people lose fingernails and toenails after recovering. When will my household’s nails be in the clear, and now that we’ve been through this once, are we immune?
September 6, 2022

My doctor recommended I take vitamin D to keep osteoporosis at bay. Now I’ve read the vitamin doesn’t do as much for bones as once thought. What gives?
August 30, 2022

I just heard about research suggesting an old vaccine might help fight off novel illnesses like Covid-19. Did I hear right?
August 23, 2022

My daughter is pregnant, and she’s asked me to get a whooping cough booster shot. If I received all the required boosters as a child, is it really necessary?
August 16, 2022

I've read that even though the monkeypox vaccine is typically given in a two-dose cycle, some cities are administering only a single dose at this time. Why? And is this an effective approach?
August 9, 2022

With highly contagious strains of the coronavirus having caused yet another surge, what is the outlook for second boosters for the general population?
August 2, 2022

Each week, OMRF Vice President of Research Dr. Rod McEver opens “Adam’s Journal” to answer a medical question from Adam Cohen, OMRF’s senior vice president & general counsel. Adam’s Journal The Food and Drug Administration recently approved another Covid-19 vaccine. What makes this shot different than the others, how effective is it, and should those […]
July 26, 2022

My son is attending a summer program in a place that is long on hot weather and short on air-conditioning. Does he need supplements to replace what he sweats out?
July 12, 2022

Each week, OMRF Vice President of Research Dr. Rod McEver opens “Adam’s Journal” to answer a medical question from Adam Cohen, OMRF’s senior vice president & general counsel. Adam’s Journal I can’t tell you the number of times someone has made a variation of the following statement to me: “Running is going to ruin your […]
July 5, 2022

I spent the better part of last week at home with what I would describe as prototypical Covid symptoms, yet each time I tested, I came back negative. What gives?
June 21, 2022

Several people I know who’ve recently come down with Covid-19 have been treated with a drug called Paxlovid. How effective is it, and are there any downsides?
June 14, 2022

Each week, OMRF Vice President of Research Dr. Rod McEver opens “Adam’s Journal” to answer a medical question from Adam Cohen, OMRF’s senior vice president & general counsel. Adam’s Journal Breakthrough infections of Covid-19 are now commonplace. Is the risk of long Covid any different among those who are fully vaccinated against the virus? Does […]
May 31, 2022

I find myself in a conundrum I’ve faced many times before: Should I lance the blister or leave it alone?
May 24, 2022

My grandmother has increased difficulty hearing, but she is hesitant to get hearing aids. If she leaves her hearing loss unchecked, could it also lead to other health problems?
May 17, 2022

Intermittent fasting, a weight loss technique that requires people to eat on a specific schedule, has gained popularity recently. Does this diet really work?
May 10, 2022

As the pandemic has eased, I’ve noticed an increase in stomach illnesses among friends and acquaintances.
April 19, 2022

I’m 35, I lost 60 pounds, eat a Mediterranean diet and exercise daily. Yet, at my physical last month, my cholesterol was still high. Can this be genetic?
April 12, 2022

Do we need to be worried about a surge of the new Covid-19 strain BA.2? Is it any worse than the original omicron variant?
March 29, 2022

Vitamin “bars,” where people get intravenous doses of vitamin and mineral solutions, seem to be trending. Is this medical fact or marketing hype?
March 22, 2022

The shingles vaccine is recommended for people ages 50 and up. Do you have to wait until you’re 50 to get vaccinated?
March 8, 2022

Each week, OMRF Vice President of Research Dr. Rod McEver opens “Adam’s Journal” to answer a medical question from Adam Cohen, OMRF’s senior vice president & general counsel. Adam’s Journal I participated in the clinical trial of the Pfizer Covid-19 vaccine, which means I received my initial shots much earlier than most people. As a […]
March 1, 2022

Recently, I experienced the worst headache I’ve ever had. The pain was so severe that I threw up. But oddly, when I vomited, the pain from the headache subsided almost immediately. Why would this be, and is it cause for concern?
February 22, 2022

After a drink or two, I notice that I fall asleep faster than usual. But, increasingly, I find that sleep doesn’t last, as I awaken in the middle of the night and often have a hard time getting back to sleep. What’s going on?
February 15, 2022

When does a mutated virus become so different from the original that it’s considered a new virus, rather than simply a variation of an existing one?
February 8, 2022

I recently ran a marathon. Do I need to worry that, at least in the short run, this kind of effort will leave my body more prone to illnesses like Covid-19?
February 1, 2022

My husband and I were fully vaccinated against Covid-19 in January 2021, and we received booster doses in October. Last month, blood tests showed we were negative for Covid-19 antibodies. Why would that be?
January 25, 2022

For much of the pandemic, cloth and surgical masks were the best many of us could get. Now that masks like the N95 and KN95 are more widely available, should we be wearing those?
January 18, 2022

For 2022, I’ve resolved to get enough sleep. But if I fall behind, what does it take to get caught back up?
January 12, 2022

The New Year brings resolutions for better health. What did medical research tell us about exercise in 2021?
January 4, 2022

“Dry January” has become increasingly popular. But does abstaining from alcohol for a single month in a year really make a difference?
December 28, 2021

For Christmas, I have a Santa’s list of health questions. First, is eggnog with raw egg safe to drink?
December 21, 2021

My teenage daughter was diagnosed with mono two weeks ago, and she still seems tired. One day she’s okay, the next she’s not. Does it really take this long to recover?
December 14, 2021

The other day, even with gloves, my fingers were so cold and numb that I had trouble unlocking my door. Is this something I need to worry about?
December 7, 2021

I recently had a respiratory infection, and the doctor prescribed a steroid. Do these medications really alleviate respiratory symptoms?
November 30, 2021

For Thanksgiving, I have some health questions. Let’s start with one I hear pretty much every year: Does eating turkey actually make you sleepy?
November 23, 2021

During a recent marathon, a friend stopped briefly to pose for a photo with family and friends. But when he did, he felt faint and nearly passed out. He went on to finish the race and reports no further problems. Is this something he needs to explore further with his doctor?
November 2, 2021

I’ve heard it said you should take an aspirin or baby aspirin a day to help prevent heart attacks and strokes. But I read that this advice has changed?
October 26, 2021

Flu shots have arrived. Is there any danger in getting a flu vaccine and a Covid-19 shot at the same time?
October 12, 2021

The Food and Drug Administration has approved Covid-19 vaccines for adults and for children and teens 12 and up. What’s taking so long for younger kids?
October 5, 2021

After my Covid-19 vaccination, the pharmacist recommended I take ibuprofen if my arm was sore the next day. Do nonsteroidal anti-inflammatory drugs such as ibuprofen interfere with the body's immune response to vaccination?
September 28, 2021

I've read about monoclonal antibodies as a treatment for Covid-19. What are they, and are they alternatives to vaccination?
September 21, 2021

I tend to draw mosquitoes like an ice cream truck does kids. While the same seems to hold true for my younger son, the bloodthirsty pests ignore my older son. What gives?
September 14, 2021

I’ve read reports of people taking a drug called ivermectin to prevent and treat Covid-19. Is this safe? And is there evidence it’s effective?
September 7, 2021

While exercising, what’s a good way to know when I’m experiencing “normal” perspiration and when I need to worry about dehydration and overheating?
August 31, 2021

The summer cold season seems worse than usual this year. Does this have something to do with the pandemic?
August 24, 2021

Should I be concerned about a high level of physical exertion while trying to stay Covid-safe?
August 17, 2021

The U.S. Food and Drug Administration still hasn’t given full approval to any of the vaccines. What’s the delay and what could
August 10, 2021

As a fully vaccinated person, how worried do I need to be about “breakthrough” infections of COVID-19?
August 3, 2021

I know people who nearly pass out at the mere sight of a needle. What causes this? Is there a way to make it stop?
July 27, 2021

Johnson & Johnson’s coronavirus vaccine may be linked to a rare side effect called Guillain-Barré syndrome. What is this syndrome?
July 20, 2021

At-home rapid COVID-19 tests are increasingly becoming available. How reliable are these tests, and how do they work?
July 13, 2021

Are those who’ve recovered from Covid-19 but remain unvaccinated protected from infection by the variant?
July 6, 2021

Each week, OMRF Vice President of Research Dr. Rod McEver opens “Adam’s Journal” to answer a medical question from Adam Cohen, OMRF’s senior vice president & general counsel and interim president. Adam’s Journal As I’ve grown older (I’m 53), I’ve noticed that I seem to be sleeping less. In particular, I tend to wake in […]
June 15, 2021

With mask restrictions rapidly loosening or disappearing, how will this affect people with compromised immune systems?
June 8, 2021

Each week, OMRF physician-scientist Dr. Eliza Chakravarty opens “Adam’s Journal” to answer a medical question from OMRF Senior Vice President and General Counsel Adam Cohen. Adam’s Journal I read that the Centers for Disease Control recently revised its guidelines for colon cancer screening. What are the new standards, and why did things change? Dr. […]
June 2, 2021

Covid nails? What’s the story, and are gnarly nails another signal you may have had the virus?
May 25, 2021

With no vaccines yet approved for people under 16, should we be concerned about youth sports?
April 13, 2021

While any form of the virus is still circulating widely in the population, it’s particularly important for older people to continue to exercise caution.
March 30, 2021

If you’ve been vaccinated with the first dose of one vaccine and get the chance to receive a second dose of the other, should you take it?
February 9, 2021

Effective masking is crucial to stopping virus transmission. Should we be doubling up?
February 2, 2021

As people have gotten their first doses of Covid-19 vaccines, many worry they won’t be able to get their second shots within the prescribed time windows.
January 26, 2021

How concerned should we be about the new strain of the coronavirus that’s emerged in the United Kingdom?
December 29, 2020

Does insomnia point to an underlying health problem? How can I get back in my old routine?
December 8, 2020

What precautions should we take to minimize the chances college students bring a viral outbreak with them during the holidays?
November 24, 2020

This year’s election really took it out of us. But are they actually bad for our health?
November 10, 2020

With holidays around the corner, many of us are thinking about visiting family or having loved ones visit us. Is it safe?
November 3, 2020

As the pandemic rolls on, do I still need to wipe groceries down once I bring them home?
October 27, 2020

We may not have a vaccine by the election, you shouldn't necessarily interpret recent news as a negative development.
October 20, 2020

Flu shots aren’t perfect, and none offer absolute protection, but you're still better off getting one.
October 14, 2020

The FDA has changed its standards for okaying coronavirus vaccines. What happened, and why does it matter?
September 29, 2020

Last week, the drug company AstraZeneca halted its SARS-CoV-2 vaccine trial. What happened?
September 15, 2020

Despite its reputation as a disease that strikes in later years, colon cancer affects people of all ages.
September 9, 2020

How does GoodRx produce such a dramatic reduction in drug prices? And shouldn’t everyone be entitled to such savings?
September 1, 2020

Adam’s Journal I recently read that the U.S. is preparing for possible “challenge” trials of coronavirus vaccines. How do these trials work, and how are they different from standard vaccine trials? Dr. Prescott Prescribes In a challenge trial, volunteers are inoculated with an experimental vaccine, which researchers have reason to believe guards against infection. Then, […]
August 25, 2020

Myocarditis is marked by symptoms that include chest pain, fatigue and shortness of breath.
August 18, 2020

Masks slow the spread of the coronavirus. And while they can’t fully protect us, there’s mounting evidence that they can lessen the severity if we do get infected.
August 4, 2020

There are a lot of accounts of antibodies rapidly disappearing once people recover from coronavirus — and leaving people prone to reinfection.
July 28, 2020

With the current surge in COVID-19 cases, it seems highly unlikely that a large community exercise event could be made safe.
July 21, 2020

As coronavirus cases have surged recently, why haven’t we seen a corresponding increase in deaths?
July 14, 2020

Should we put off routine dental appointments in light of the current coronavirus situation? Or is it safe?
June 30, 2020

Can you get coronavirus from the toilet? This is going to make you want to wash your hands.
June 23, 2020

Are temperature checks an effective tool for controlling the spread of the coronavirus?
June 16, 2020

Rallies across the country have seen thousands of people packed together. Should we expect to see a surge in coronavirus cases as a result?
June 9, 2020

Scientists are currently conducting at least a half-dozen clinical studies to see whether smart watches and other wearable technology can offer early indicators of SARS-CoV-2 infection.
June 2, 2020

There are reports of a new syndrome in children infected with the coronavirus. Should all parents be concerned about it?
May 19, 2020

What are the chances that using plasma transfusion from COVID-19 survivors will work in treating the critically ill?
April 14, 2020

Will this virus go away as we move from spring into summer? And if so, is it likely to reappear in the fall and winter?
March 24, 2020

What, exactly, is the coronavirus? How worried do we all need to be? And what practical steps can we take to protect ourselves?
March 9, 2020

Bruising can be caused by any number of minor traumas. This is particularly true as we get older and our skin thins.
March 3, 2020

With the rapid spread of the coronavirus, concerns are mounting. OMRF Drs. Prescott and James are here to address them.
March 1, 2020

With the rapid spread of the coronavirus, readers have understandably voiced their concerns about this emerging viral threat.
March 1, 2020

Is it safe to get the vaccinations for the flu, pneumonia, shingles, and so on if you have a history of Guillan-Barré syndrome?
February 18, 2020

On Valentine’s Day, the world celebrates love. But it’s easy to forget that Cupid’s arrow can cut, too.
February 14, 2020

Cancer remains a daunting foe. But the odds of surviving this terrible disease should continue to improve.
January 21, 2020

Good vision is its own reward. But in a larger sense, does a person’s ocular health also tell us anything about our overall health?
January 14, 2020